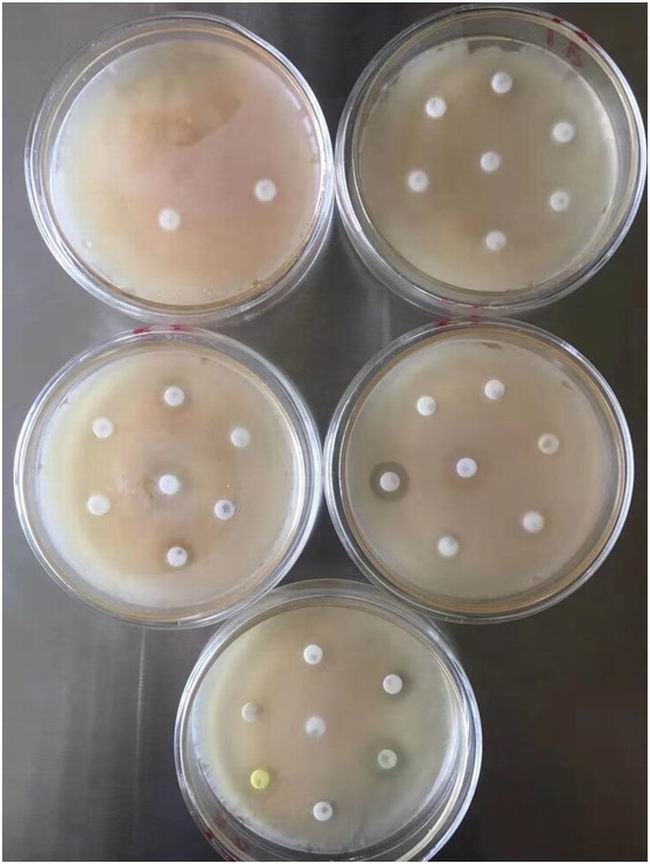
B378A8D3-4B1A-4512-A27B-682B2DAFDC0B.JPG
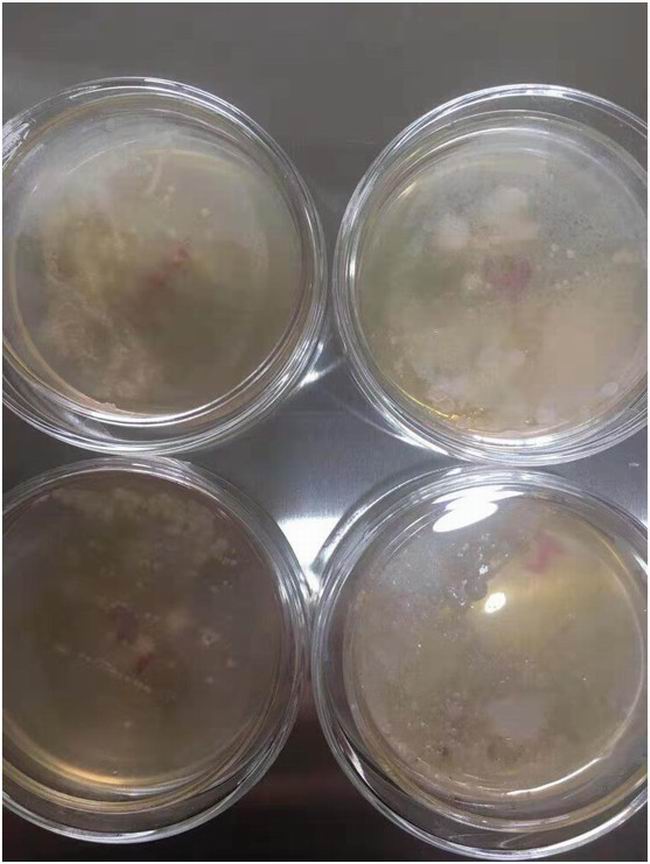
55593F14-49F6-4A45-BF88-1436FF28159C.JPG
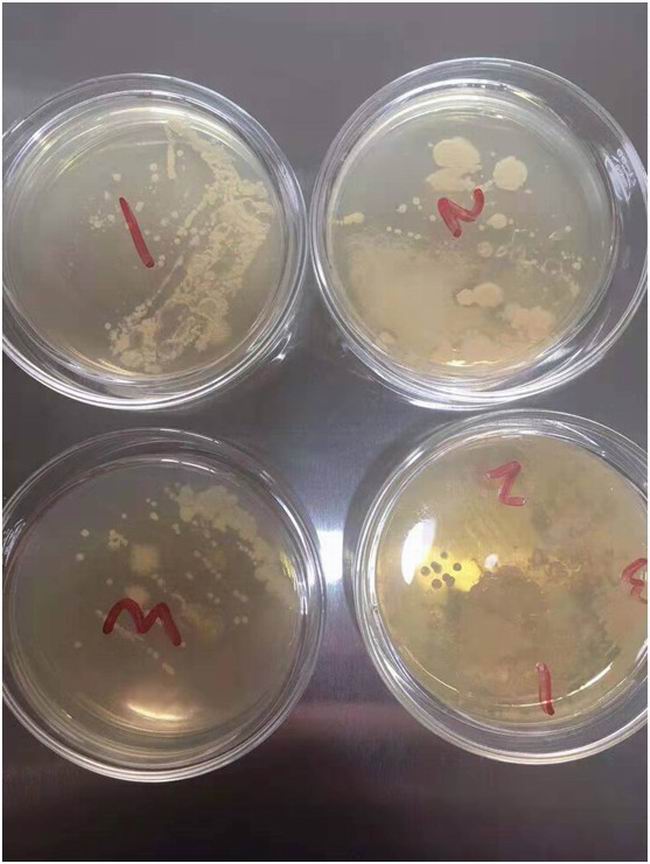
217EB584-4437-4B73-B52D-5406BFE451EE.JPG

產品分類
聯系我們
CONTACT US
電 話:0379-69939365
手 機:15670312561
地址:洛陽市洛龍區洛宜路與學子街交叉口西200米
乘車路線:乘坐84路到洛宜路學子街口西下車
洛陽偃師諸葛村綿羊養殖戶羊群咳嗽流鼻涕,治療多天無效,并有傳染性,來我院進行藥敏試驗。

本文是【http://m.eunaosouamelia.com 洛陽市洛龍區澳科動物醫院】原創,轉載時請務必以鏈接形式注明作者和出處
地 址:http://m.eunaosouamelia.com/home-newsinfo-id-92.html